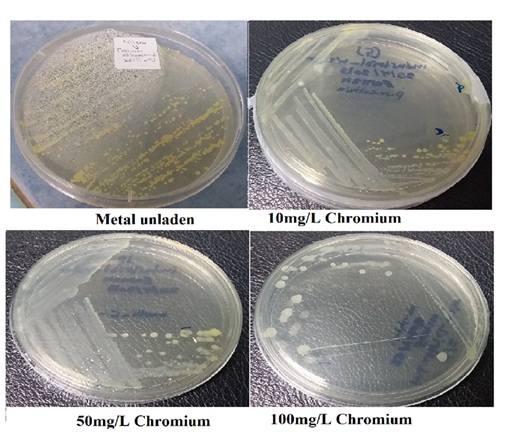

Physiological of Bacteria in Removing Metal Ions from Wastewater
Normala Halimoon, Eeman Assadeg Alhammadi
INTRODUCTION
The remarkable increases in industrial production activities over the last several decades have resulted in the release of huge quantities of effluents containing high levels of heavy metals into natural environments. These include metal plating, steel production, and chemical industries (Zhenggang et al., 2019). Wastewater from manufacturing or chemical processes in industries contributes to water pollution. Surface water is the primary dumping medium for waste disposal, as it was found that one-third of water pollution comes from sewage discharge (Akpor et al., 2014). Industrial wastewater usually contains specific chemical compounds, mainly toxic waste, including inorganic pollutants. Environmental pollution of heavy metals is a significant problem, most notably from electroplating industries that mostly produce effluents containing heavy metals (Singh et al., 2016).
HEAVY METALS IN ELECTROPLATING EFFLUENTS
Electroplating effluents contain a wide range of heavy metals that are difficult to decay naturally in the environment. Zinc, nickel, cadmium, chromium, lead, copper, arsenic, and others are found in high concentrations in industrial electroplating effluent (Liu et al., 2022). It was reported that effluent from electroplating factories, which may contain high concentrations of copper (Cu), nickel (Ni), chromium (Cr), and zinc (Zn), is a significant source of metallic pollution (Xiao et al., 2019). High levels of metals, chemical oxygen demand (COD), and other persistent toxic substances are produced during electroplating operations, including cyanides, nitrates, and sulfate complexes. It was found that anywhere from 2 to 20% of the chemicals used, along with valuable metals and cyanide, are lost in wastewater, which eventually raises the amount of pollutants (Rajoria et al., 2021). Metallurgical industry discharge compounds have been reported to contain metals such as Cr, Ni, and Zn (Singh et al., 2016).
BIOLOGICAL ROLE AND TOXICITY OF HEAVY METALS
Some metals are essential for living cells in trace amounts, such as Fe, Co, Cu, Cr, Mo, Mn, Se, Ni, and Zn, but become toxic at higher concentrations. Others, such as Sb, Pb, Hg, and Ag, are not required by living cells and are toxic even at low levels (Bąk et al., 2019). Cu, Ni, and Zn are elements that exhibit biological significance for living cells but in trace quantities and are required for normal cellular growth. These metals play an important role as "trace elements" in sophisticated biochemical reactions that are essential and required in low concentrations. However, all heavy metals in high concentrations have harmful effects on living cells.
IMPACT OF HEAVY METALS ON MICROBIAL SYSTEMS
Biologically, Cr is an important nutrient because it is involved in electron transport systems, but microbes are very sensitive to both excess and deficiency of Cr and its compounds (Ayele and Godeto, 2021). Zn shows antioxidant properties against the formation and alleviation of free radicals and reactive oxygen species, contributing to protein stability. Zn is an essential nutrient in living systems, with more than 5% of bacterial proteins depending on it (Rahman and Karim, 2018).
Ni has been described as essential for the growth of living cells, including microorganisms (Begum et al., 2022). Nickel-based enzymes are well known in archaea, bacteria, algae, and primitive eukaryotes, playing a major role in microbial function (Genchi et al., 2020). Similarly, Cu is a pivotal micronutrient in biological processes, serving as a cofactor for enzymes such as cytochrome C oxidase (Irawati et al., 2021). However, at higher concentrations, Cu induces cytotoxicity, leading to lipid peroxidation, substitution of metal ions in proteins, and oxidation of essential protein groups (Irawati et al., 2021). Copper can also damage soil, water, and air ecosystems. Cr exposure can alter bacterial morphology, metabolism, and DNA structure, ultimately inhibiting enzyme activity and oxidative phosphorylation (Ayele and Godeto, 2021).
BIOREMEDIATION OF HEAVY METALS USING METAL-RESISTANT BACTERIA
Several physical, chemical, and biological treatment methods have been used to ensure effective treatment of contaminated water, despite increased levels of heavy metals (Hamdan et al., 2021). However, the limitations of conventional methods for treating heavy metals in industrial effluents have led to growing interest in microorganisms for bioremediation. The natural properties of bacteria enable them to absorb and accumulate heavy metals, as microbial species possess the ability to capture and accumulate heavy metals from water solutions (Yadav et al., 2017). Bacterial cell walls have an anionic structure with active sites that facilitate metal binding (Igiri et al., 2018). Using bacteria as a cost-effective and innovative method holds promise as a biomass-based technology for metal removal from contaminated environments.
MECHANISMS OF HEAVY METAL RESISTANCE IN BACTERIA
Multi-metal-resistant bacteria employ different mechanisms for detoxification and uptake of heavy metals (Nanda et al., 2019). These bacteria can absorb metal ions on their cell surface (biosorption) or take them up intracellularly (bioaccumulation). Their survival in contaminated environments relies on biochemical characteristics and physiological adaptations to tolerate metal stress. Bacteria use toxic metals as an energy source for essential physiological processes such as fermentation, respiration, and co-metabolism (Timková, 2018). Additionally, pigment production in bacterial cells is part of these physiological responses.
IMPACT OF HEAVY METALS ON DENITRIFICATION PROCESSES
Wastewaters containing high heavy metal concentrations often have elevated nitrate and nitrite levels (Rajta et al., 2019). These metal ions can interfere with microbial metabolism, affecting the ability of bacteria to reduce nitrate. Nitrate pollution is a common environmental issue, particularly in groundwater systems near sewage plants and industrial areas (Moloantoa et al., 2022). High nitrate levels can cause eutrophication and algal blooms in surface waters, reducing water quality and ecosystem stability (Niu et al., 2021). Therefore, assessing the ability of metal-resistant bacteria to carry out denitrification under heavy metal stress is crucial for bioremediation.
OPTIMIZATION OF BIOSORPTION PARAMETERS
To enhance the effectiveness of multi-metal-tolerant bacteria for biosorption, it is essential to optimize biosorption conditions in aqueous solutions (Cai et al., 2018). The co-biosorption study of metals can be conducted individually and in combination using single bacterial strains and bacterial consortia under optimum parameters such as pH, biomass dosage, contact time, and temperature. Biosorption efficiency depends on these factors (Rasmey et al., 2018). Isothermal, kinetic, and thermodynamic studies should also be performed to better understand the biosorption mechanisms.
EXPERIMENTAL ANALYSIS OF BIOSORPTION EFFICIENCY
Nine bacterial species were identified and tested at concentrations of 10–50 mg/L of copper, zinc, nickel, and chromium, both as individual metals and in a quaternary metal solution. Growth kinetics, resistance, and biosorption capacity were determined. The most tolerant isolates, including biosorption, bioaccumulation, and physiological activity under metallic stress, were selected for further evaluation.
The biosorption characteristics and optimum conditions were investigated using Langmuir, Freundlich, Tempkin, and Dubinin-Radushkevich isotherms. Kinetics models such as Pseudo-first-order, Pseudo-second-order, Elovich, and Intra-particle diffusion were analyzed. Thermodynamic parameters were determined, and bacterial adsorbents were further characterized using Fourier Transform Infrared (FTIR) spectroscopy and Scanning Electron Microscopy (SEM).
CONCLUSION
The isolated bacteria exhibited significant multi-metal resistance, with bacterial consortia being the most efficient. Biosorption and bioaccumulation rates varied according to metal type and contact time. Despite a decline in physiological activity with increasing metal concentrations, bacterial metabolism and viability persisted under stress. The findings confirm the potential of metal-resistant bacteria as effective biosorbents for industrial wastewater treatment.
REFERENCES
Akpor, O., Ohiobor, G. and Olaolu, T. (2014). Heavy metal pollutants in wastewater effluents: Sources, effects and remediation. Advances in Bioscience and Bioengineering, 2(4), 37-43.
Ayele, A. and Godeto, Y.G. (2021). Bioremediation of chromium by microorganisms and its mechanisms related to functional groups. Journal of Chemistry :21. https://www.hindawi.com/journals/jchem/2021/7694157.
Begum, W., Rai, S., Banerjee, S., Bhattacharjee, S., Mondal, M. H., Bhattarai, A. and Saha, B. (2022). A comprehensive review on the sources, essentiality and toxicological profile of nickel. RSC advances, 12(15), 9139–9153. https://doi.org/10.1039/d2ra00378c.
Bąk, Ł., Szeląg, B., Górski, J., and Górska, K. (2019). The Impact of Catchment Characteristics and Weather Conditions on Heavy Metal Concentrations in Stormwater—Data Mining Approach. Applied Sciences, 9(11), 2210. https://doi.org/10.3390/app9112210.
Cai, Y., Li, X., Liu, D., Xu, C., Ai, Y., Sun, X., Zhang, M., Gao, Y., Zhang, Y., Yang, T., Wang, J., Wang, L., Li, X. and Yu, H. A. (2018). Novel Pb-Resistant Bacillus subtilis Bacterium Isolate for Co-Biosorption of Hazardous Sb (III) and Pb (II): Thermodynamics and Application Strategy. Int. J. Environ. Res. Public Health 2018, 15, 702.
Genchi, G., Carocci, A., Lauria, G., Sinicropi, M. S. and Catalano, A. (2020). Nickel: Human Health and Environmental Toxicology. International journal of environmental research and public health, 17(3), 679. https://doi.org/10.3390/ijerph17030679.
Giachino, A. and Waldron, K. J. (2020). Copper tolerance in bacteria requires the activation of multiple accessory pathways. Molecular microbiology, 114(3), 377–390. https://doi.org/10.1111/mmi.14522.
Hamdan, A.M., Abd-El-Mageed, H. and Ghanem, N. (2021). Biological treatment of hazardous heavy metals by Streptomyces rochei ANH for sustainable water management in agriculture. Sci Rep 11, 9314 . https://doi.org/10.1038/s41598-021-88843-y.
Igiri, B. E., Okoduwa, S., Idoko, G. O., Akabuogu, E. P., Adeyi, A. O. and Ejiogu, I. K. (2018). Toxicity and Bioremediation of Heavy Metals Contaminated Ecosystem from Tannery Wastewater: A Review. Journal of toxicology, 2018, 2568038. https://doi.org/10.1155/2018/2568038.
Irawati, W., Djojo, E. S., Kusumawati, L., Yuwono, T. and Pinontoan, R. (2021). Optimizing Bioremediation: Elucidating Copper Accumulation Mechanisms of Acinetobacter sp. IrC2 Isolated From an Industrial Waste Treatment Center. Frontiers in microbiology, 12, 713812. https://doi.org/10.3389/fmicb.2021.713812.
Liu, P. C.,Vilando, A. C. and Lu, M. C.(2022). Treatment of synthetic zinc and nickel wastewater and identification of its crystallization products by fluidized bed homogeneous crystallization technology. Process Safety and Environmental Protection. 164,154-163. https://doi.org/10.1016/j.psep.2022.05.066.
Moloantoa, K.M., Khetsha, Z.P., van Heerden, E., Castillo, J.C. and Cason, E.D. (2022). Nitrate Water Contamination from Industrial Activities and Complete Denitrification as a Remediation Option. Water , 14, 799. https:// doi.org/10.3390/w14050799.
Nanda, M., Kumar, V. and Sharma, D. K. (2019). Multimetal tolerance mechanisms in bacteria: The resistance strategies acquired by bacteria that can be exploited to 'clean-up' heavy metal contaminants from water. Aquatic toxicology (Amsterdam, Netherlands), 212, 1–10. https://doi.org/10.1016/ j.aquatox.2019.04.011.
Niu, C.; Zhai, T.; Zhang, Q.; Wang, H. and Xiao, L. (2021). Research Advances in the Analysis of Nitrate Pollution Sources in a Freshwater Environment Using δ 15N-NO3 − and δ 18O-NO3 −. Int. J. Environ. Res. Public Health , 18, 11805. https://doi.org/10.3390/ ijerph182211805.
Nwanyanwu, C.E., Adieze, I.E., Nweke, C.O and Nzeh, B.C. (2017). Combined effects of metals and chlorophenols on dehydrogenase activity of bacterial consortum. Inter. Res. J. Biol. Sci. 6(4), 10-20.
Rahman, M. T. and Karim, M. M. (2018). Metallothionein: a Potential Link in the Regulation of Zinc in Nutritional Immunity. Biological trace element research, 182(1), 1–13. https://doi.org/10.1007/s12011-017-1061-8.
Rajoria, S., Vashishtha, M. and Sanga, V. K. (2021). Review on the treatment of electroplating industry wastewater by electrochemical methods. Materials Today: Proceedings, 47, 1472-1479.https://doi.org/10.1016/j.matpr.2021.04.165.
Rajta, A., Bhatia, R., Setia, H. and Pathania, P. (2019). Role of heterotrophic aerobic denitrifying bacteria in nitrate removal from wastewater. Sfam, 128(5), 1261-1278. https://doi.org/10.1111/jam.14476.
Rasmey, A., Aboseidah, A. and Youssef, A. (2018). Application of Langmuir and Freundlich Isotherm Models on Biosorption of Pb2+ by Freez-dried Biomass of Pseudomonas aeruginosa. Egyptian Journal of Microbiology, 53(1), 37-48. doi: 10.21608/ejm.2018.2998.1050.
Singh, V., Ram, C. and Kumar, A. (2016). Physico-Chemical Characterization of Electroplating Industrial Effluents of Chandigarh and Haryana Region. Journal of Civil & Environmental Engineering, 6(4), 237–242. doi: 10.4172/2165-784X.1000237.
Tarekegn, M. M., Salilih, F. Z. and Ishetu, A. I. (2020). Microbes used as a tool for bioremediation of heavy metal from the environment. Cogent Food Agric 6: 1783174.
Timková, I., Sedláková-Kaduková, J. and Pristaš, P. (2018). Biosorption and bioaccumulation abilities of actinomycetes/streptomycetes isolated from metal contaminated sites. Separations, 5(4), 54.DOI: 10.3390/separations5040054.
Xiao, L., Guan, D., Chen, Y., Dai, J., Ding, W., Peart, M. R. and Zhang, C. (2019). Distribution and availability of heavy metals in soils near electroplating factories. Environmental science and pollution research international, 26(22), 22596–22610. https://doi.org/10.1007/s11356-019-04706-0.
Yadav, K., Gupta, N., Kumar, V. and Singh, J. (2017). Bioremediation of Heavy Metals From Contaminated Sites Using Potential Species. Indian Journal of Environmental Protection( IJEP), 37 (1), 65-84.
Zhenggang, X., Yi, D., Huimin, H., Liang, W., Yunlin, Z. and Guiyan, Y. (2019). Biosorption Characteristics of Mn (II) by Bacillus cereus Strain HM-5 Isolated from Soil Contaminated by Manganese Ore. Pol. J. Environ. Stud. Vol. 28, No. 1 (2019), 463-472.
Figure 1: The Pigment Color Under Metallic Stress (Chromium Stress)